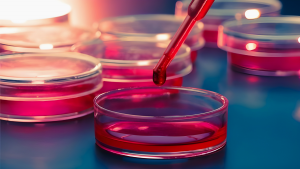

Known for its pale pink body and Mona Lisa-like smile, the Mexican axolotl (Ambystoma mexicanum) is a figure of intrigue. Affectionately nicknamed “water monsters”, axolotls are eerie creatures that have burrowed their way into the hearts of many people.1 Their protruding frill-like gills and lidless eyes have been known to captivate and repulse people alike, but their mutant-like ability to perfectly regenerate limbs can be accredited to their rise to fame, both in history and in contemporary times (See Figure 1).
Axolotls first gained recognition during the time of the Aztecs. While building their city Tenotchtitlan in modern-day Mexico City, the Aztecs cooperated with the natural wetlands and canals, shaping them to facilitate the growth of their city while still maintaining their natural features. Axolotls thrived during these times, and featured prominently in Aztec myths. One of the most notable legends is that of Xolotl, the god of fire and lighting, as well as the god of sickness and deformities, and how he chose to transform himself into an axolotl to escape being sacrificed by the other gods. Although his endeavor failed and he ultimately perished, the axolotl was named in his honor.2 Today, the axolotls are most famous for their unique quality of regenerating their tissues. They can grow back limbs, organs, spinal cords, and even parts of their brains without a single trace of scarring. This ability makes them incredibly valuable in the world of medical research. Discovering what aspects of their biology grants them this miracle would lead to significant leaps in human medicine. 3

Wild axolotl populations began to be monitored in the 1990s. They had decreased from 6,000 individuals per square kilometer in 1998 to 100 individuals per square kilometer in 2008.6 This number then dropped to 35 individuals per square kilometer in 2015. This drastic reduction in wild axolotls is concerning, especially considering they are an endemic species, meaning they can only be naturally found in one spot in the world. In the decades since these revelations, three main threats to axolotl populations have been identified: the urbanization of their natural habitat, the decline of water quality, and the introduction of exotic, predatory fish.7
The axolotl’s native habitat is the wetlands of Xochimilco in Mexico City, an area of about 40 square kilometers. It consists of canals interwoven among chinampas, small rectangular island-like pieces of land traditionally used to grow crops by farmers (See Figure 2). These chinampas formed part of the traditional Aztec style of farming, and the axolotl coexisted alongside them. However, in the centuries after the fall of the Aztec empire, these aquatic habitats began to be dismissed in favor of more contemporary styles of farming and urbanization.8 The wetlands were drained of their water and replaced with buildings and roads. Previously home to wild axolotls, Lake Chalco in Mexico City was drained completely to expand the city and assuage worries of flooding among citizens.9

Today, agricultural runoff from the chinampas and nearby farms, which includes pesticides and fertilizer, inundates these wetlands, creating a eutrophic environment. Eutrophic means that the environment is so nutrient-heavy that plant growth is overwhelming and absorbs all the oxygen, suffocating native animal species like the axolotl.12 As if this weren’t enough, pollution from Mexico City often also enters the wetlands. Overflows from the sewage system are common and they can be catastrophic to the animal populations in Xochimilco, particularly the axolotl. Heavy metals, ammonia, oils, and other toxins common in runoff from urban areas can penetrate their permeable skin and cause significant damage as exposure grows. 13
Axolotl eggs and young are particularly vulnerable, as their development is negatively impacted by these toxins. The contamination in the water has been found to lead to methemoglobinemia, a condition that lowers the activity levels of the axolotls and interferes with their natural behaviors. Pollution obstructs their sense of smell, thereby interfering with their hunting habits. Although deformities in axolotls have not occurred yet, researchers believe that if contamination rates continue, it might only be a matter of time until deformities are documented.14
Not only have the urbanization and decrease in water quality affected the axolotls, but invasive fish species have been introduced to these wetlands, displacing the role of the axolotls in their ecosystem. Nile tilapia (Oreochromis niloticus) and common carp (Cyprinus carpio) were initially introduced into Xochimilco to provide more fishing opportunities, but competition with the axolotl soon led to trouble. These invasive fish species devour the eggs, larvae, and juveniles of axolotls. Not satisfied with merely eating axolotls, they also compete with them when hunting for prey. Studies have found that axolotls catch less prey in the presence of tilapia and carp due to the competition, as well as the fact they spend valuable energy avoiding the path of these predators. The presence of these fishes has not only affected the number of axolotl individuals but also their size and growth rate, since their dietary habits have been disrupted.15

- “Mexico City’s ‘water Monster’ Nears Extinction.” 2008. NBC News. November 2, 2008. https://www.nbcnews.com/id/wbna27503150. ↵
- Voss, S. Randal, M. Ryan Woodcock, and Luiz Zambrano. 2015. “A Tale of Two Axolotls.” BioScience 65 (12): 1134-40. doi:10.1093/biosci/biv153. ↵
- “Axolotl | National Geographic.” 2010. Animals. October 9, 2010. https://www.nationalgeographic.com/animals/amphibians/facts/axolotl. ↵
- Дарья, Уткина. 2014. Русский: Аксолотль- Неотеническая Личинка Некоторых Видов Амбистом, Земноводных Из Семейства Амбистомовых. Own work. https://commons.wikimedia.org/wiki/File:%D0%90%D0%BA%D1%81%D0%BE%D0%BB%D0%BE%D1%82%D0%BB%D1%8C_%D0%BC%D0%B5%D0%BA%D1%81%D0%B8%D0%BA%D0%B0%D0%BD%D1%81%D0%BA%D0%BE%D0%B9_%D0%B0%D0%BC%D0%B1%D0%B8%D1%81%D1%82%D0%BE%D0%BC%D1%8B_%28Ambystoma_mexicanum%29.jpg. ↵
- “Ambystoma Mexicanum (Axolotl).” n.d. Accessed February 28, 2023. https://www.iucnredlist.org/species/1095/53947343. ↵
- Alcaraz, Guillermina, Xarini López-Portela, and Cecilia Robles-Mendoza. 2015. “Response of a Native Endangered Axolotl, Ambystoma Mexicanum (Amphibia), to Exotic Fish Predator.” Hydrobiologia 753 (1): 73–80. https://doi.org/10.1007/s10750-015-2194-4. ↵
- Voss, S. Randal, M. Ryan Woodcock, and Luiz Zambrano. 2015. “A Tale of Two Axolotls.” BioScience 65 (12): 1134-40. doi:10.1093/biosci/biv153. ↵
- Voss, S. Randal, M. Ryan Woodcock, and Luiz Zambrano. 2015. “A Tale of Two Axolotls.” BioScience 65 (12): 1134-40. doi:10.1093/biosci/biv153. ↵
- “Mexico City’s ‘water Monster’ Nears Extinction.” 2008. NBC News. November 2, 2008. https://www.nbcnews.com/id/wbna27503150. ↵
- Simon, Gael. 2006. English: Canals in Xochimilco Français: Canaux à Xochimilco Español: Canales En Xochimilco Brezhoneg: Kanoloù e Xochimilco. Own work. https://commons.wikimedia.org/wiki/File:Chinampas_Xochimilco.jpg. ↵
- Voss, S. Randal, M. Ryan Woodcock, and Luiz Zambrano. 2015. “A Tale of Two Axolotls.” BioScience 65 (12): 1134-40. doi:10.1093/biosci/biv153. ↵
- Magazine, Smithsonian. n.d. “How to Save the Paradoxical Axolotl.” Smithsonian Magazine. Accessed March 28, 2023. https://www.smithsonianmag.com/science-nature/saving-paradoxical-axolotl-180967734/. ↵
- Fessl, Sophie. 2018. “The Race to Save the Axolotl.” JSTOR Daily. April 25, 2018. https://daily.jstor.org/the-race-to-save-the-axolotl/. ↵
- Chaparro-Herrera, Diego de Jesus, Sarma Nandini, and S. S. S. Sarma. 2013. “Effect of Water Quality on the Feeding Ecology of Axolotl Ambystoma Mexicanum.” Journal of Limnology 72 (3): e46–e46. https://doi.org/10.4081/jlimnol.2013.e46. ↵
- Alcaraz, Guillermina, Xarini López-Portela, and Cecilia Robles-Mendoza. 2015. “Response of a Native Endangered Axolotl, Ambystoma Mexicanum (Amphibia), to Exotic Fish Predator.” Hydrobiologia 753 (1): 73–80. https://doi.org/10.1007/s10750-015-2194-4. ↵
- LaDameBucolique. 2017. English: Axolotl 🙂. https://pixabay.com/photos/axolotl-leucistique-male-ambystoma-2193331/. https://commons.wikimedia.org/wiki/File:Axolotl-2193331_1280.webp. ↵
- Voss, S. Randal, M. Ryan Woodcock, and Luiz Zambrano. 2015. “A Tale of Two Axolotls.” BioScience 65 (12): 1134-40. doi:10.1093/biosci/biv153. ↵

23 comments
Peter Alva
This is such a well-written article and I am glad that I am finally finding out what these are. for a long time, I have seen pictures of them but never understood what they were or even where they come from and it’s cool to find out that they come straight out of Mexico. I think its important to keep native species like the Axolotl’s because it gives the area an identity and a reason to keep its native lands.
Alanna Hernandez
First off “ Mona Lisa like smile “ had me dead.I was not aware of the prominence they held amongst the Aztecs but did see axolotl have some prominence in my childhood completely unaware of the threat they faced I just thought they were rare. It is definitely heartbreaking to think about urbanization’s direct Threat to them. Congrats on the nomination you earned it with the clear and well thought article.
Barbara Ortiz
Congratulations on your nomination for such a great article. In our house we love the axolotl. My daughter, who is 5, has an ABC book of peculiar creatures and this of course is A. So of course I had to share with her all about your article and she wanted to know more about what you wrote. So I shared about their habitat shrinking and she got really sad. So I do hope the Mx government does step up with a policy to protect them.
Gabriella Galdeano
Congratulations on your nomination! I really liked your writing style and the pictures you used of the different axolotl. I did not know that they regenerate their tissues. Discovering how they do this could be huge in medicine. It is scary how quickly their population is decreasing, but hopefully, the government will start aiding in their conservation.
Iris Reyna
Congrats on your article nomination, you picked a fascinating topic to write about, who doesn’t adore these little creatures? I’ve always wanted to get one for a pet but the main point was that they were just adorable. I really didn’t know much about them. To learn that axolotl’s native habitat is in the wetlands of Xochimilico in Mexico City and how the rate of deterioration of habitats increases significantly is sad. Then later the water was polluted and longer safe for the axolotl as well as the invasive species that decrease the populations. It’s good to know that there are scientists and citizens who are fighting for their refuge and salvation of the axolotls.
Hunter Stiles
Congrats on your nomination! I remember when I first saw one of these, and I think they are so cool! Finding out more about axolotls was fantastic. It’s shocking that I hadn’t heard of them before given how amazing their talents are. Since I’m sure others would be interested in studying them to understand more about regeneration, I’d have assumed the campaign to save them would be more well-known and better supported. Infatuation on the scale of the lizard guy from Spiderman. Anyway, this essay was excellent! And I’m glad to be on the side of their sweetness rather than their unique looks.
Well done !
Marissa Rendon
This is a specific article that goes into detail about why axolotls are being threatened. This article truly got me engaged into axolotls, this was a very easy article to understand. Congratulations on your award nomination !
Madison Magaro
Congratulations on your publication! This article was very well written and put together. I have never heard about axolotls and it is sad to see that they are being threatened. It is crazy that people are urbanizing the one place that axolotls can live and it is slowly killing off their species. This was a great informative article and it was a good read.
Hailey Koch
Congrats on the nomination for your article, you chose a very interesting topic and I loved being able to read it and learn more about these fascinating creatures. I have seen pictures of Axolotls before but I never knew their name or the history of them. It’s crazy how rare where they come from was, that you could only find them producing there. It sounds devastating that the wetlands had to be trained for building and streets to be built. Great job on your article it was not only very informative, but it was really interesting to read!
Anayetzin Chavez Ochoa
Oh, the dopey axolotl, what an amazing creature! They’re so meme-able and cute, it only makes me want to save their species more. I know they can regenerate their limbs very slowly. I like to think of them as Mexico’s mascot besides the Xolo and Chihuahua. I hope we can save their species and all the other creatures which may be affected!